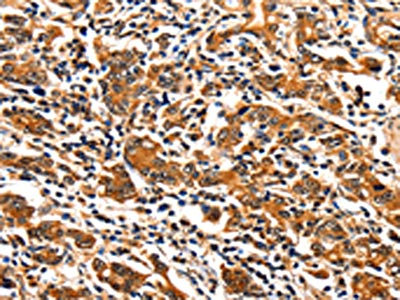

-
中文名稱:ITGAM兔多克隆抗體
-
貨號:CSB-PA073350
-
規格:¥1100
-
圖片:
-
The image on the left is immunohistochemistry of paraffin-embedded Human gastic cancer tissue using CSB-PA073350(ITGAM Antibody) at dilution 1/10, on the right is treated with synthetic peptide. (Original magnification: ×200)
-
The image on the left is immunohistochemistry of paraffin-embedded Human liver cancer tissue using CSB-PA073350(ITGAM Antibody) at dilution 1/10, on the right is treated with synthetic peptide. (Original magnification: ×200)
-
-
其他:
產品詳情
-
Uniprot No.:
-
基因名:
-
別名:antigen CD11b (p170) antibody; Antigen CD11b p170 antibody; CD11 antigen like family member B antibody; CD11 antigen-like family member B antibody; CD11b antibody; CD11b/CD18 antibody; CD49d antibody; Cell surface glycoprotein MAC-1 subunit alpha antibody; Complement component 3 receptor 3 subunit antibody; Complement Component Receptor 3 Alpha antibody; Complement receptor type 3 antibody; Complement receptor type 3, alpha subunit antibody; CR 3 alpha chain (CR3A) antibody; CR 3 alpha chain antibody; CR-3 alpha chain antibody; CR3 antibody; CR3A antibody; F730045J24Rik antibody; Integrin Alpha M antibody; Integrin alpha M chain antibody; Integrin alpha-M antibody; Integrin beta 2 alpha subunit antibody; Integrin subunit alpha M antibody; integrin, alpha M (complement component 3 receptor 3 subunit) antibody; ITAM_HUMAN antibody; ITGAM antibody; Leukocyte adhesion receptor MO1 antibody; Ly-40 antibody; MAC 1 antibody; Mac-1a antibody; MAC1 antibody; Mac1, alpha subunit antibody; MAC1A antibody; Macrophage antigen alpha polypeptide antibody; MGC117044 antibody; Mo1 antibody; Mo1, alpha subunit antibody; MO1A antibody; Neutrophil adherence receptor alpha M subunit antibody; Neutrophil adherence receptor antibody; SLEB6 antibody
-
宿主:Rabbit
-
反應種屬:Human
-
免疫原:Synthetic peptide of Human ITGAM
-
免疫原種屬:Homo sapiens (Human)
-
標記方式:Non-conjugated
-
抗體亞型:IgG
-
純化方式:Antigen affinity purification
-
濃度:It differs from different batches. Please contact us to confirm it.
-
保存緩沖液:-20°C, pH7.4 PBS, 0.05% NaN3, 40% Glycerol
-
產品提供形式:Liquid
-
應用范圍:ELISA,IHC
-
推薦稀釋比:
Application Recommended Dilution ELISA 1:1000-1:2000 IHC 1:10-1:50 -
Protocols:
-
儲存條件:Upon receipt, store at -20°C or -80°C. Avoid repeated freeze.
-
貨期:Basically, we can dispatch the products out in 1-3 working days after receiving your orders. Delivery time maybe differs from different purchasing way or location, please kindly consult your local distributors for specific delivery time.
-
用途:For Research Use Only. Not for use in diagnostic or therapeutic procedures.
相關產品
靶點詳情
-
功能:Integrin ITGAM/ITGB2 is implicated in various adhesive interactions of monocytes, macrophages and granulocytes as well as in mediating the uptake of complement-coated particles and pathogens. It is identical with CR-3, the receptor for the iC3b fragment of the third complement component. It probably recognizes the R-G-D peptide in C3b. Integrin ITGAM/ITGB2 is also a receptor for fibrinogen, factor X and ICAM1. It recognizes P1 and P2 peptides of fibrinogen gamma chain. Regulates neutrophil migration. In association with beta subunit ITGB2/CD18, required for CD177-PRTN3-mediated activation of TNF primed neutrophils. May regulate phagocytosis-induced apoptosis in extravasated neutrophils. May play a role in mast cell development. Required with TYROBP/DAP12 in microglia to control production of microglial superoxide ions which promote the neuronal apoptosis that occurs during brain development.
-
基因功能參考文獻:
- A significant reduction of CD11b expression on monocytes and granulocytes, as a sign of reduced cellular inflammation, was achieved by treatment of atrial fibrillation using pulmonary vein isolation. PMID: 28073885
- Expression of Mac-1 on the surface of human embryonic kidney (HEK) 293 cells induced their adhesion and migration to PTN. Accordingly, PTN promoted Mac-1-dependent cell spreading and initiated intracellular signaling manifested in phosphorylation of Erk1/2. PMID: 28939773
- CD11b rs1143679 polymorphism appears to be associated with risk for SLE in the Han Chinese population, and may play an important role in the development of lupus nephritis. PMID: 29207897
- alphaMbeta2 uses its alphaI domain to bind iC3b at the thioester domain and simultaneously interacts through a region near the alphaM beta-propeller and beta2 betaI domain with a region of the C3c moiety near the C345C domain. PMID: 28292891
- Up-regulation of granulocyte and monocyte CD11b during plasma separation was C5-dependent. PMID: 29575196
- This study shown the ITGAM expression in Microglia and Astrocytes in stroke, Alzheimer's disease, and Lewy body dementia. PMID: 28398520
- CD11b expression on polymorphonuclear leukocytes from patients with ankylosing spondylitis stimulated with lipopolysaccharide is not different to that of healthy controls. PMID: 24373176
- The use of CD33(+)CD11b(+)HLA-DR(-) cells as a predictive and prognostic biomarker. PMID: 27178742
- Bone marrow mesenchymal stromal cells induce the rapid differentiation of CD11b+ myeloid cells from bone marrow progenitors, and such an activity requires the expression of nitric oxide synthase-2. PMID: 28183849
- demonstrate for the first time a dependency of monocyte-platelet aggregates and CD11b expression on monocytes in the presence of atrial fibrillation (AF) and support the notion of a close relationship between AF, thrombogenesis and inflammation PMID: 26763077
- Increased CD11b+ and CD200+ monocytes in those with a strong presence of BVN indicate that BVN development may be associated with retinal injury and a VEGF-mediated process that is either reflected or propelled by systemic changes in monocytes. PMID: 29049725
- This study, we provide evidence supporting a crucial pathogenic role for alphaM-integrin (CD11b) in acute inflammatory demyelinating polyradiculoneuropathy mononuclear leukocyte trafficking. PMID: 27460017
- TLR-stimulated macrophages from CD11B SNP carriers showed increased basal expression of IFN regulatory factor 7 (IRF7) and IFN-beta, as well as increased nuclear exclusion of FOXO3, which was suppressed by LA1-dependent activation of CD11b. PMID: 28263189
- FRbeta as a novel CD11b/CD18 regulator for trafficking and homing of a subset of macrophages on collagen. PMID: 27534550
- this study shows that upregulation of CD11b after stimulation with IL-8 is more pronounced in adults than in neonates, whereas fMLP induces changes in receptor expression that are of the same magnitude in neutrophils from neonates as from adults PMID: 27606963
- Ingestion of amino acid supplement did not influence CD11b expression. PMID: 27384580
- This metaanalysis indicates that polymorphisms in the pathways of immune complex clearance, such as the FcgammaRIIIa, FcgammaRIIIb, and ITGAM genotypes, are potential susceptibility genes for neuropsychiatric systemic lupus erythematosus. PMID: 26773105
- Monocyte-platelet aggregates and CD11b expression on monocytes and granulocytes are increased in atrial fibrillation patients with proven thrombus formation. They seem to be appropriate biomarkers for stratification of thromboembolic risk in patients with AF. PMID: 26411420
- CD11b immunophenotyping identifies inflammatory profiles in the mouse and human lungs. PMID: 26422753
- There is direct interaction between C3(H2O) and CD11b. Contact-activated C3(H2O) is a novel ligand for CD11b/CD18 that mediates platelet-PMN complex formation and the binding of platelet-derived microparticles to PMNs. PMID: 26293614
- increased in neonates with abnormal neuroimaging and/or severe neonatal encephalopathy PMID: 25655529
- Data show that secreted aspartic protease 2 (Sap2) of Candida albicans inactivates human macrophage complement factor H (factor H), factor H-receptors CD11b/CD18 and CD11c/CD18. PMID: 26306739
- we confirmed the similarities between epithelial ovarian cancer and fallopian tube, normal and adenocarcinoma using FOLR1, FOLR2, CD68 and CD11b markers PMID: 25971554
- While total surface expression of CD11b and L-selectin on neutrophils was largely unaffected PMID: 26361072
- CD11b expression level might be considered a prognostic biomarker for Acute Myeloid Leukemia patients. [meta-analysis] PMID: 26309131
- analysis of neutrophil and monocyte expression of toll-like receptor 4, CD11b and reactive oxygen intermediates, and correlation with neuroimaging outcomes in preterm infants PMID: 25826119
- The rs1143679 polymorphism is associated with systemic lupus erythematosus susceptibility in different ethnic groups and with lupus nephritis in Europeans. No association was found with rheumatoid arthritis. [Meta-Analysis] PMID: 25315704
- the results identify dynorphins A and B as novel ligands for Mac-1. PMID: 26036990
- A novel expanding CD11b+ conventional dendritic cell subpopulation dominates the infiltrating renal inflammatory milieu, localizing to the glomeruli, in lupus nephritis. PMID: 26512111
- Modification of Levels of Adhesion Molecule Expression of Human Innate Immune Cells by Glycopolymers of Marine Bacteria PMID: 26852488
- study supports the crucial role of GABP in myeloid cell differentiation and identified ITGAM/CD11b as a novel GABP target gene PMID: 26170143
- Data indicate that Candida albicans beta-Glucan induces high IL-1 receptor antagonist (IL-1Ra) levels, independently from Dectin-1/complement receptor 3 (CR3). PMID: 25461401
- A novel association of common variable immunodeficiency have been found with rare variants at the FUS/ITGAM (CD11b) locus on 16p11.2. PMID: 25678086
- role of CD11b/CD18 in priming of human leukocytes by endotoxin glycoforms from Escherichia coli PMID: 25365491
- Il-6-induced recruitment of CD11b+ CD14+ HLA-DR- myeloid-derived suppressor cells is associated with progression and poor prognosis in squamous cell carcinoma of the esophagus. PMID: 25238263
- Results show the functional importance of integrin alpha M (ITGAM) in systemic lupus erythematosus (SLE) pathogenesis through impaired phagocytosis. PMID: 24886912
- Examination of CR3 ( CD11b/CD18)mutant variants and mass spectrometry analysis of the N-glycosylation pattern of CR3 revealed that N-glycans located in the C-terminal part of the CD11b subunit are involved in binding and cytotoxic activity of CyaA. PMID: 25554420
- newly revealed recognition specificity of alpha(M)beta2 toward unfolded protein segments and cationic proteins and peptides suggests that alpha(M)beta2 may serve as a previously proposed "alarmin" receptor with important roles in innate host defense PMID: 25613106
- The HNA-1b allotype influences the Fc gamma RIIIb cooperation with Fc gamma RIIa, but not with CR3. PMID: 24945596
- The altered expression levels of ITGAM and FCgammaRIIIA mRNA in systemic lupus erythematosus patients and their correlations with clinical data suggest that ITGAM and FCgammaRIIIA may play a role in this disease. PMID: 23708937
- The transcript levels of ITGAM significantly decreased for the systemic lupus erythematosus risk allele (A) relative to the non-risk allele (G), in a dose-dependent fashion. PMID: 24608226
- A new genome-wide significant association between ITGAM-ITGAX and IgA nephropathy. PMID: 25305756
- A negative correlation was found between CD11b percentage and postinfarct left ventricular ejection fraction. PMID: 25136078
- hnRNP K in PU.1-containing complexes recruited at the CD11b promoter: a distinct role in modulating granulocytic and monocytic differentiation of AML-derived cells. PMID: 25005557
- This suggests that FcgammaRIIIb signals in association with macrophage-1 Ag. PMID: 25024378
- Although CD11b was more frequently expressed in blast cells of patients with intermediate and unfavorable cytogenetic risk groups, this feature did not translate into different clinical outcome. PMID: 24782118
- circulating trisomy 12 CLL cells also have increased expression of the integrins CD11b, CD18, CD29, and ITGB7, and the adhesion molecule CD323. PMID: 24829201
- integrin alpha9beta1/CD11B levels in circulating neutrophils are significantly elevated in pneumonia patients PMID: 23257917
- genetic polymorphism is associated with systemic lupus erythematosus in Brazilian patients PMID: 24269694
- Complement receptor 3 (CR3) inhibition impairs phagocytosis of serum-opsonized zymosan but has little impact on phagocytosis of unopsonized zymosan in the absence or presence of lipopolysaccharide. PMID: 24726062
顯示更多
收起更多
-
相關疾病:Systemic lupus erythematosus 6 (SLEB6)
-
亞細胞定位:Cell membrane; Single-pass type I membrane protein. Membrane raft; Single-pass type I membrane protein.
-
蛋白家族:Integrin alpha chain family
-
組織特異性:Predominantly expressed in monocytes and granulocytes. Expressed in neutrophils (at protein level).
-
數據庫鏈接:
Most popular with customers
-
YWHAB Recombinant Monoclonal Antibody
Applications: ELISA, WB, IHC, IF, FC
Species Reactivity: Human, Mouse, Rat
-
Phospho-YAP1 (S127) Recombinant Monoclonal Antibody
Applications: ELISA, WB, IHC
Species Reactivity: Human
-
-
-
-
-
-